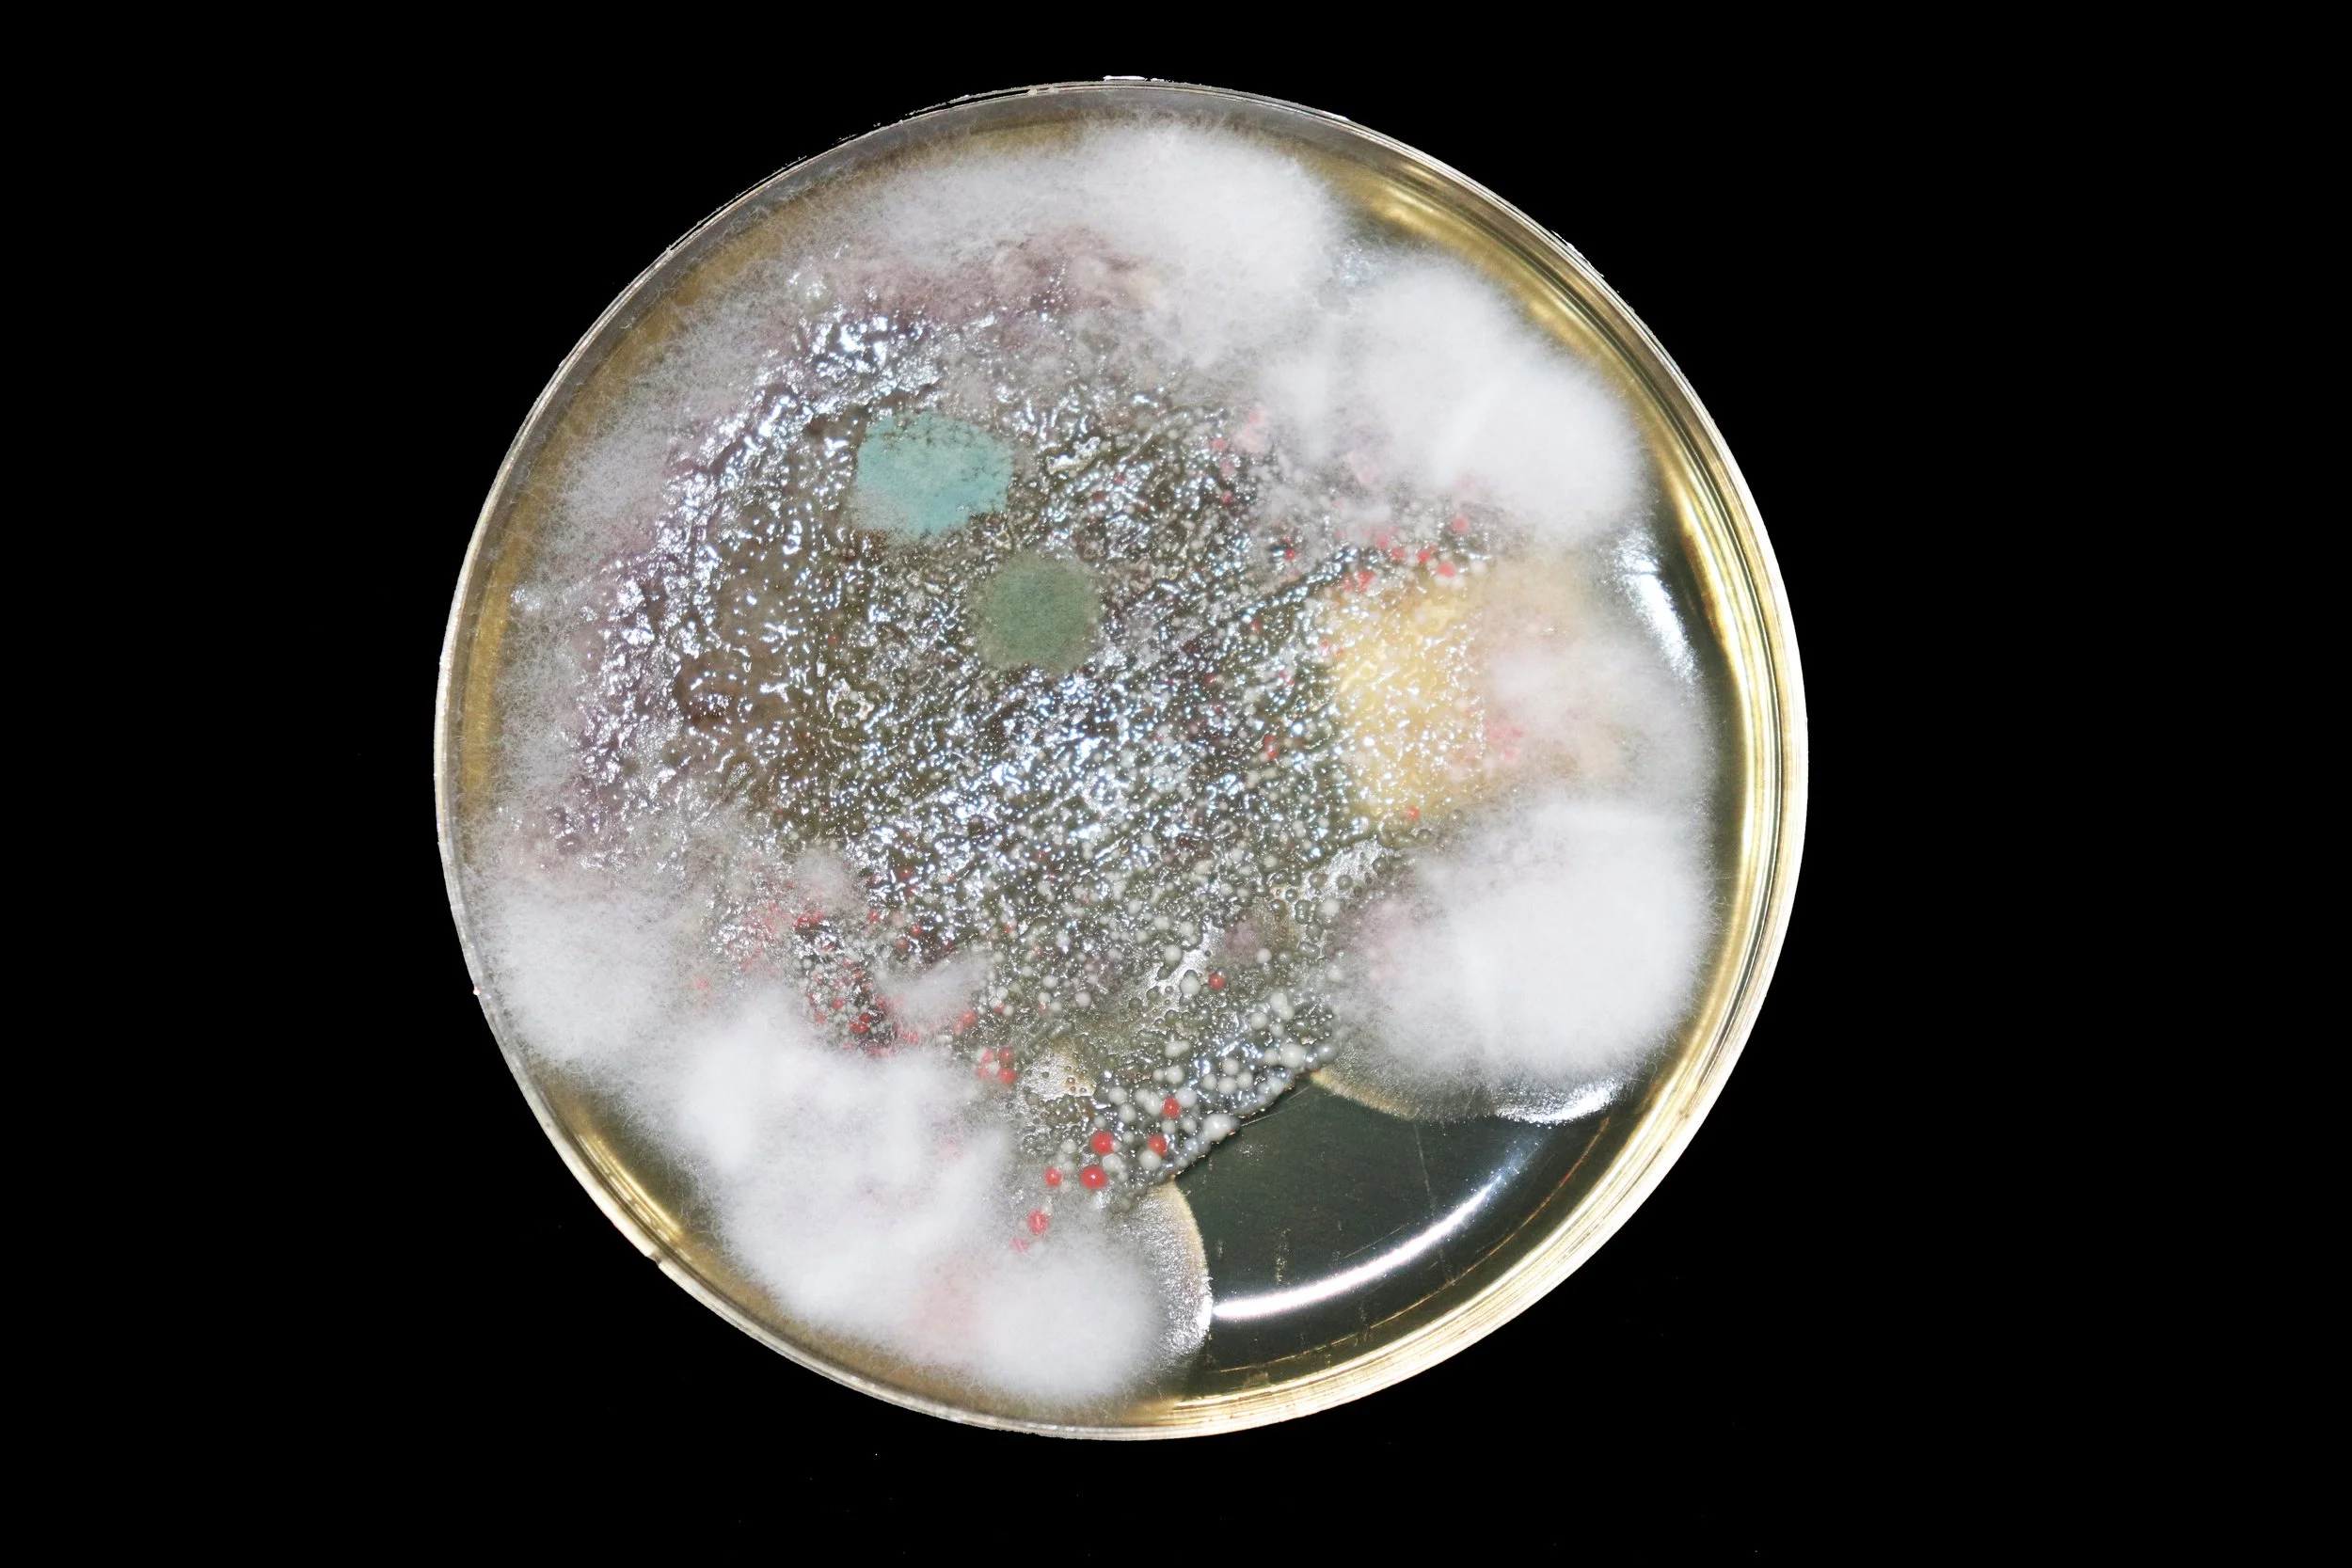
5.jpg
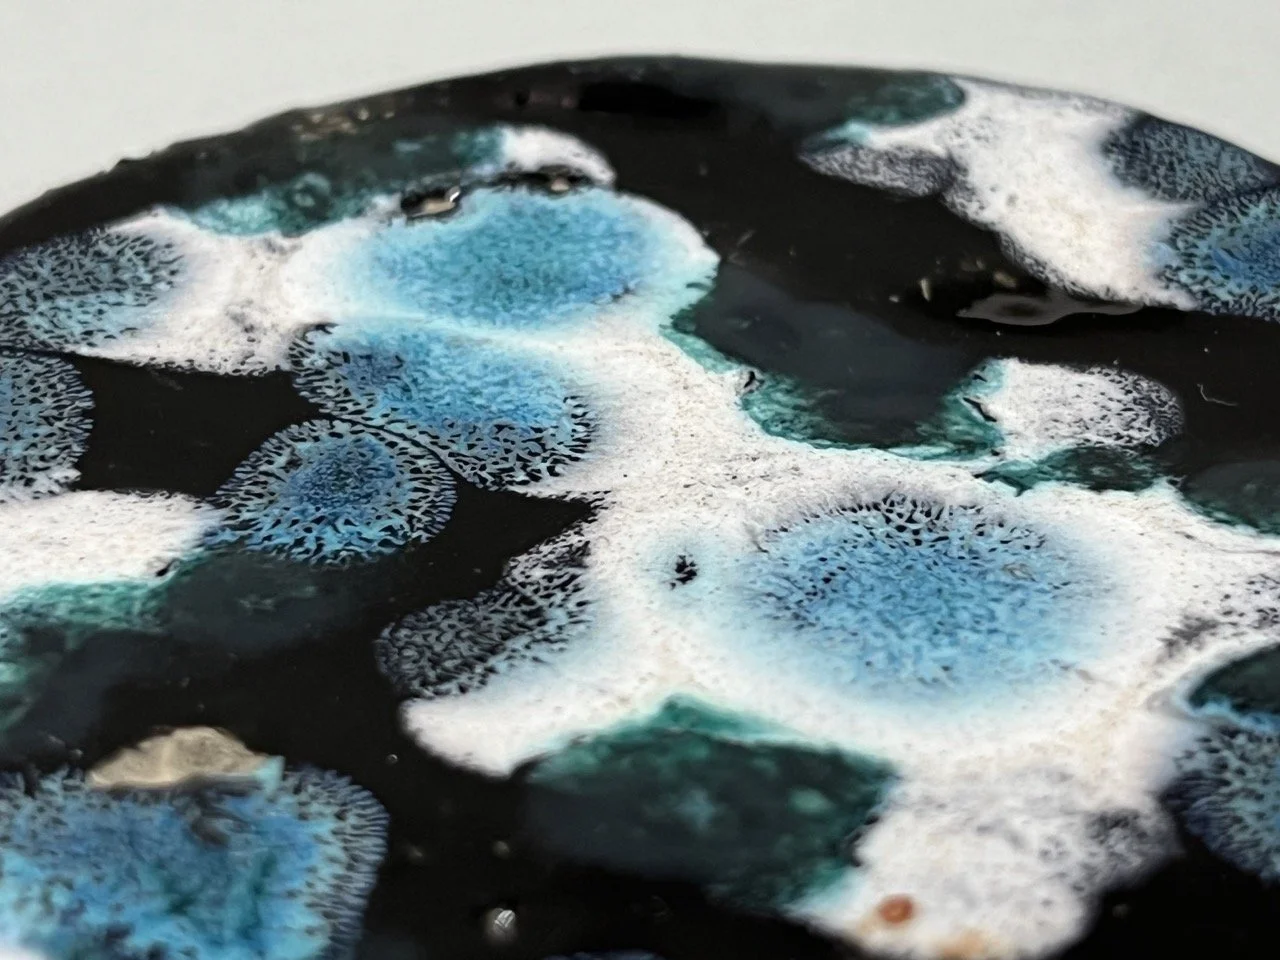
IMG_9860 Large.jpeg

Fungi
//
Fungi //
The beauty of post-mortem.

the mold as inspiration

the carpet, ceramics and embroidery







